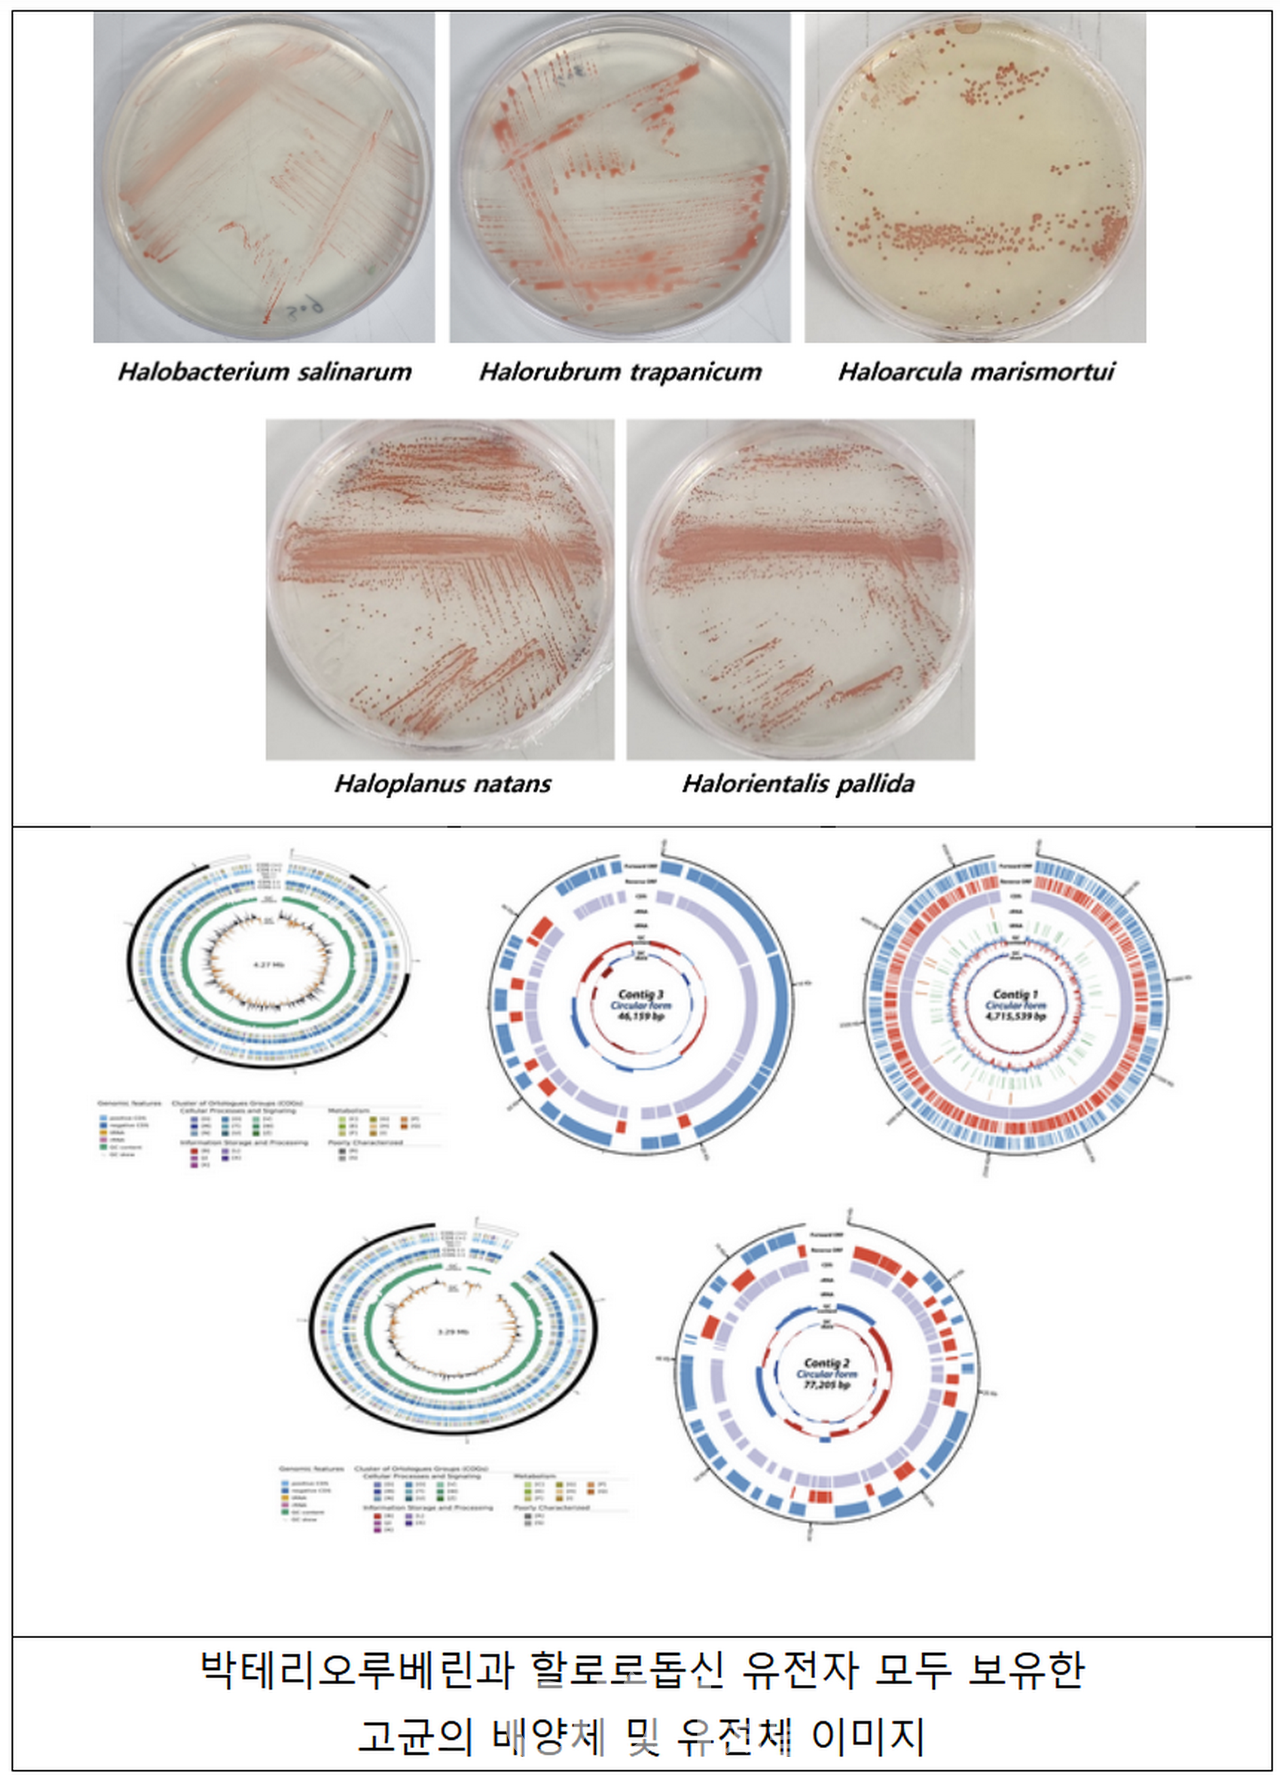

인천의 염전에서 발견된 미생물이 피부 건강과 신경 안정에 획기적인 가능성을 제시했다. 환경부 소속 국립생물자원관 연구진은 염전에서 채취한 호염성 고균 11종에서 자외선 차단과 항산화 효과를 가진 붉은색 유기 색소 ‘박테리오루베린’ 생산 유전자와 신경세포 흥분 억제를 유도하는 유전자를 찾아냈다. 이 발견은 국내 자생 생물을 활용해 고가의 수입 소재를 대체할 수 있는 새로운 가능성을 열었다.

이번 연구는 ‘자생생물의 환경 적응 및 진화 유전자 연구 사업’의 일환으로 진행됐다. 연구진은 할로박테리움강(Halobacteria)에 속하는 호염성 고균의 유전체를 분석하여 강력한 항산화 색소인 박테리오루베린을 생산하는 유전자를 가진 11종의 고균을 확인했다. 박테리오루베린은 호염성 고균이 자외선과 극한 환경으로부터 생존하도록 돕는 물질로, 면역 강화, 노화 방지, 피부 건강 유지 등 다양한 기능성 소재로 활용될 수 있다.
특히 이들 중 5종의 고균은 빛을 이용해 신경세포의 활성을 제어할 수 있는 유전자를 보유하고 있었다. 이 유전자는 광유전학적 연구에서 사용되는 단백질 ‘할로로돕신(Halorhodopsin)’의 생산을 가능하게 한다. 할로로돕신은 해외 연구에서 쥐의 신경세포 흥분을 억제하는 데 성공하며 신경 안정 치료에 활용 가능성을 보인 바 있다.
박테리오루베린은 이미 해외에서 항노화와 피부 보호를 목적으로 한 고급 화장품 원료로 사용되고 있다. 이번 발견은 이를 수입에 의존하지 않고 국내 자생 미생물로 대체할 수 있는 기회를 제공한다. 또한, 할로로돕신 관련 연구는 뇌과학과 신경 질환 치료에서의 응용 가능성을 열어줄 것으로 기대된다.
국립생물자원관은 발견된 11종의 호염성 고균에 대한 연구 결과를 내년 상반기 국제 학술지에 발표할 예정이다. 이후 기능성 소재로 상용화된 해외 미생물을 대체하기 위한 심화 연구를 진행할 계획이다. 이를 통해 국내 생물자원의 경제적 가치를 높이고, 기능성 소재 시장에서 경쟁력을 강화하고자 한다.
자생 미생물을 활용한 이번 연구는 단순한 발견을 넘어 환경과 생태계를 기반으로 한 자원 활용의 미래를 제시한다. 국립생물자원관은 앞으로도 유용한 생물 자원을 발굴하고 이를 활용한 다양한 연구를 지속적으로 추진할 계획이다.

'환경' 카테고리의 다른 글
| 2025년 푸른 뱀의 해, 1월의 멸종위기 야생생물 ‘구렁이’ 선정 (0) | 2025.01.02 |
|---|---|
| 대기오염물질 배출량 공개, 산불과 미세먼지의 역습 (2) | 2024.12.17 |
| 멸종위기 철새들의 낙원, 무안 갯벌 보호구역 2.7배 확대 (2) | 2024.12.09 |
| 수질오염 해결책, 신종 미생물이 답! 96시간 내 완전 분해 (3) | 2024.12.04 |
| 자연에서 찾은 항생제 내성 해결책, 뚜껑덩굴의 효능 (0) | 2024.09.19 |
댓글